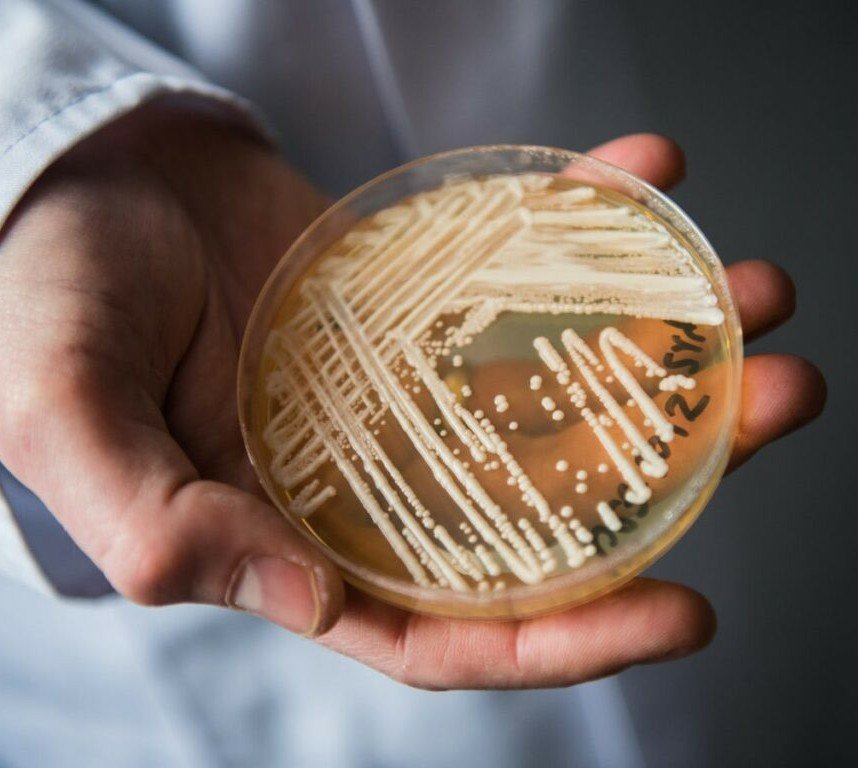

Two clusters of untreatable Candida auris infections have been detected in Texas and Washington, D.C., since January, according to the CDC’s latest Morbidity and Mortality Weekly Report published July 23.

It’s the first time the fungus has been detected in people who never received antifungal medication, suggesting it may have spread from person to person.
From January to April, three pan-resistant infections were reported in a Washington nursing home and two were reported at two Texas hospitals that share patients. The CDC did not identify the facilities where the outbreaks occurred and said there was no link between the two clusters. Some reports indicate they were in Dallas area hospitals.
The three Washington infections were detected after screening 101 C. auris cases, while the two Texas infections were detected after screening 22 cases.
“These two simultaneous, independent clusters of pan- or echinocandin-resistant C. auris cases in patients with overlapping inpatient healthcare exposures and without previous echinocandin use provide the first evidence suggesting that pan- or echinocandin-resistant C. auris strains might have been transmitted in U.S. healthcare settings,” the CDC said.
______________________
Get Your Natural Vitamins A & D from the Sea!

Get Your Natural Vitamins A & D from the Sea!
______________________